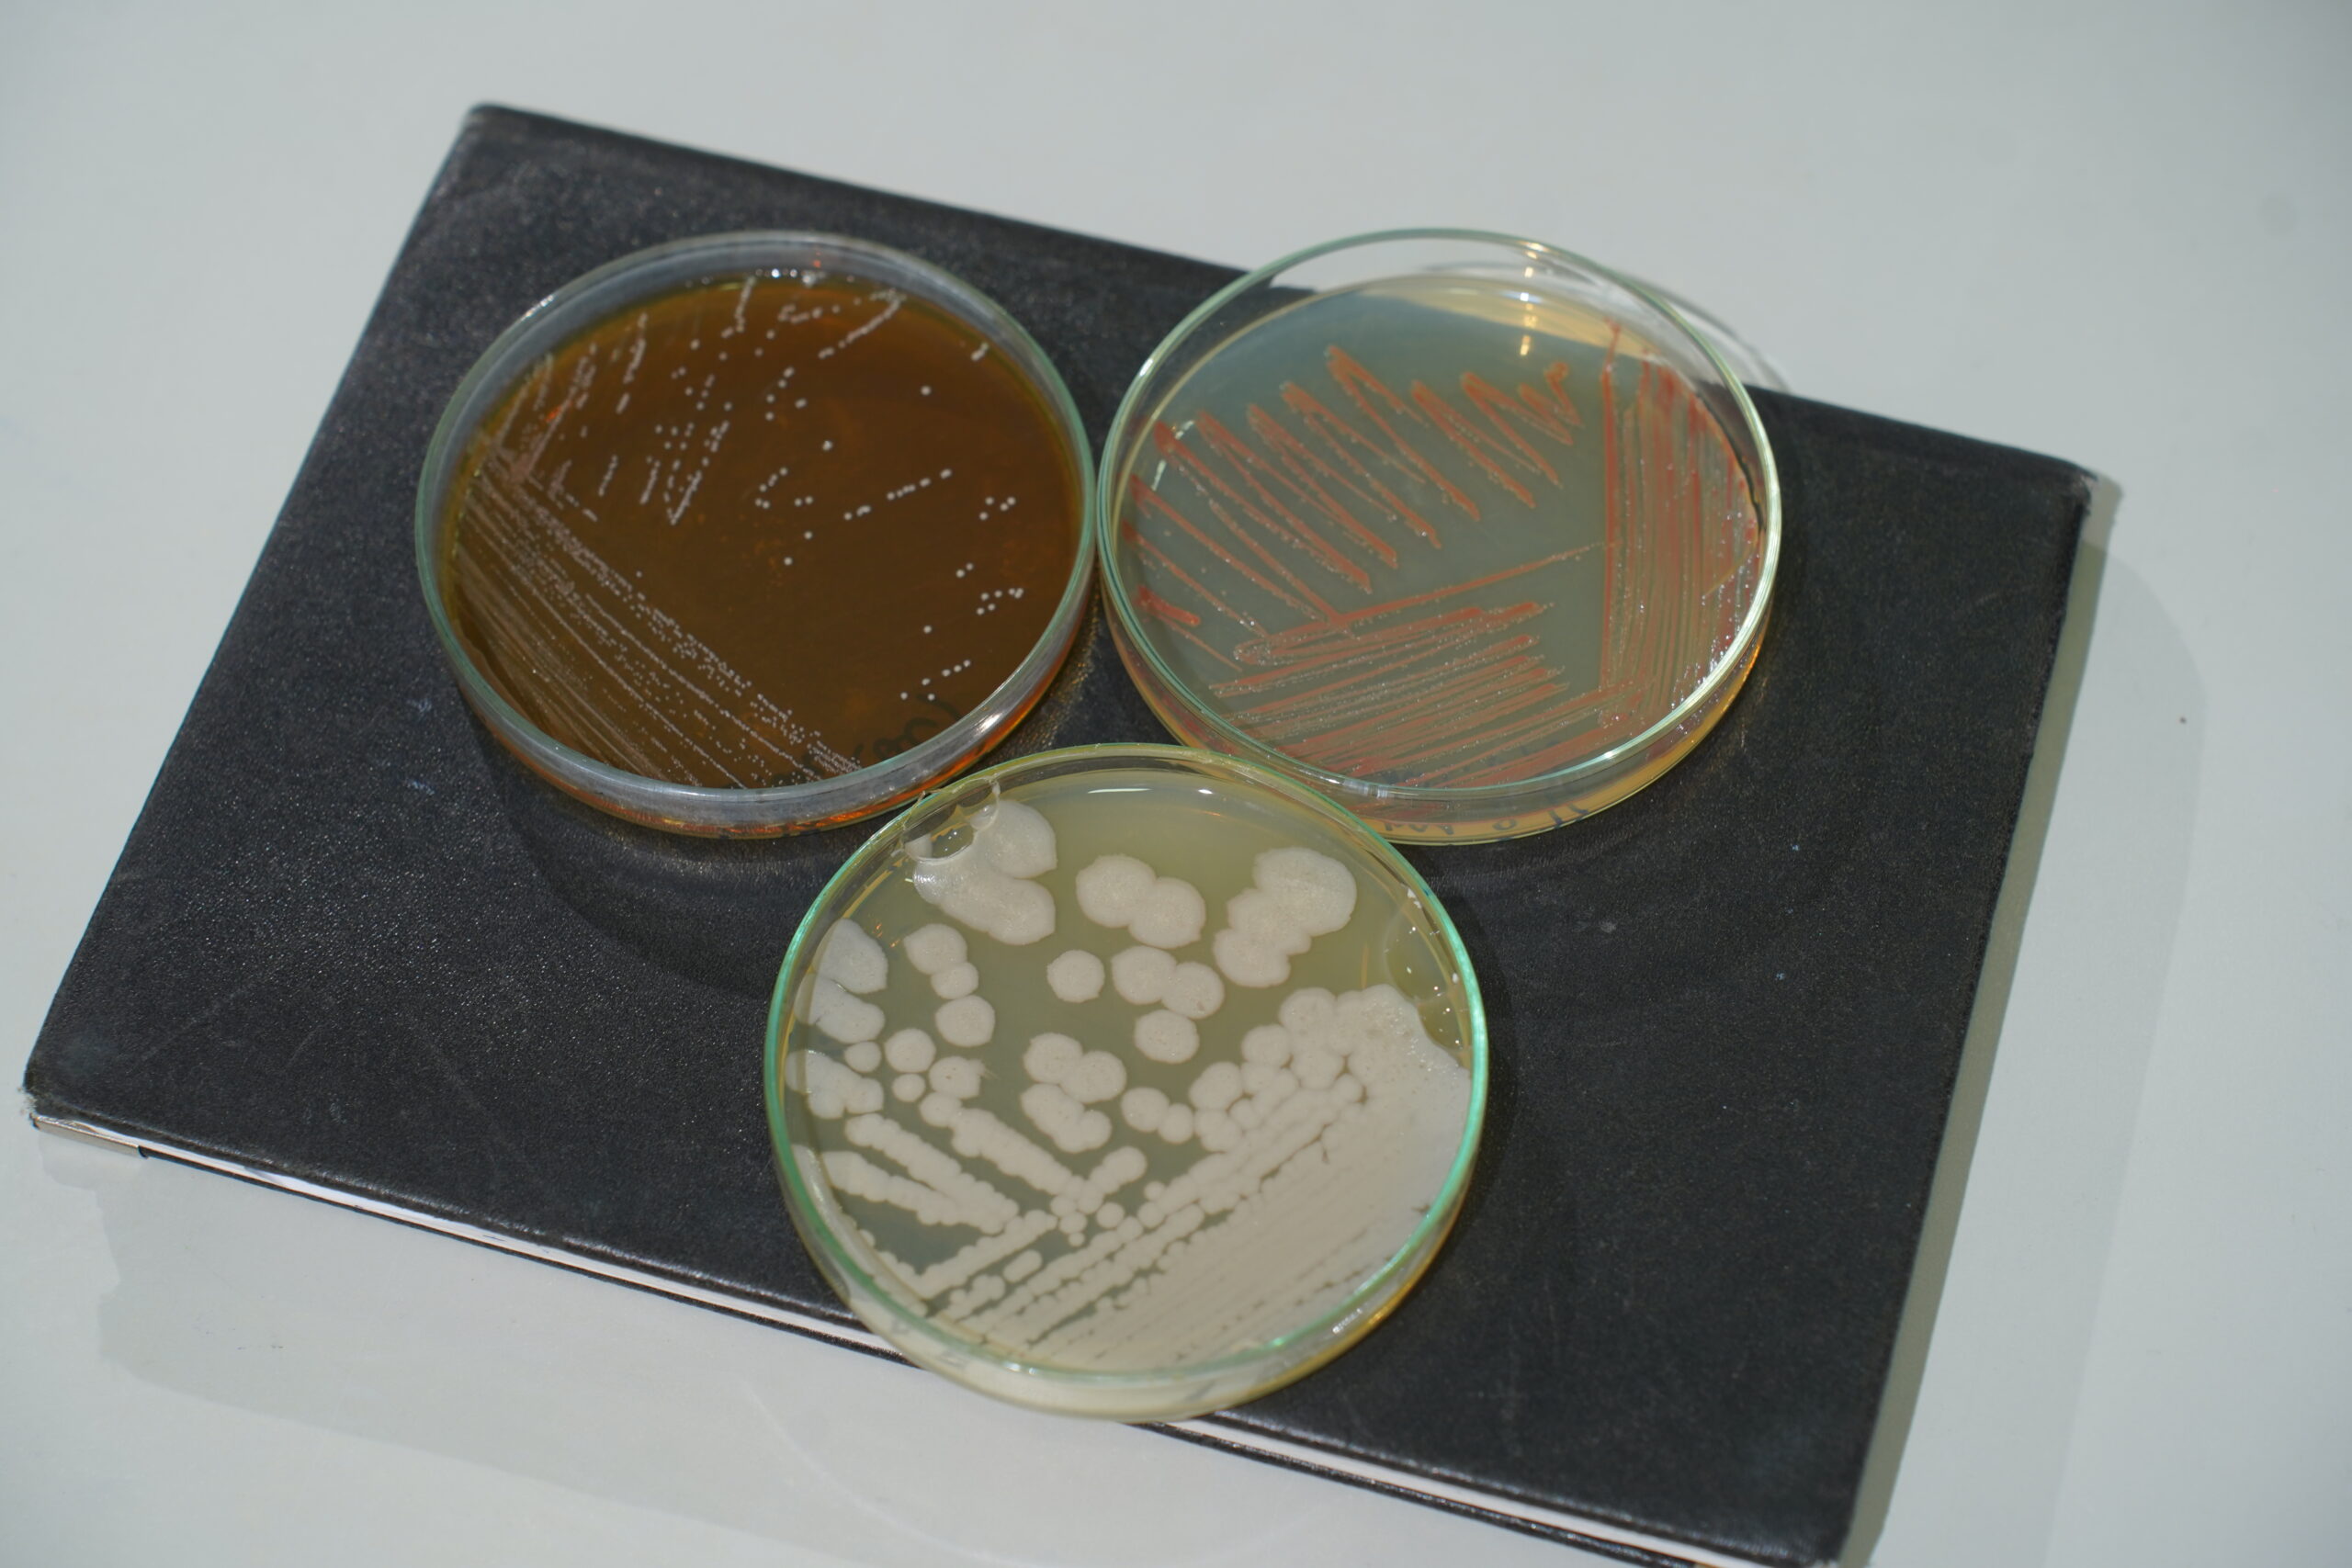
công nghệ bảo quản chủng gốc

Contents
Công nghệ bảo quản chủng gốc để giữ hoạt tính tốt nhất tại Bio-Floc
Trong sản xuất chế phẩm vi sinh, nguồn giống gốc (chủng vi sinh vật) chính là nền móng quyết định chất lượng sản phẩm. Một chủng vi sinh chỉ phát huy tối đa giá trị khi duy trì được hoạt tính sinh học, tính ổn định di truyền qua thời gian.
Tại Bio-Floc, mọi sản phẩm đều bắt đầu từ nguồn giống đạt chuẩn, được bảo quản ở nhiệt độ siêu lạnh -86°C. Đây là công nghệ hiện đại hàng đầu, được các trung tâm nghiên cứu và nhà máy vi sinh tiên tiến trên thế giới áp dụng – đã có mặt trong hệ thống sản xuất của Bio-Floc tại Việt Nam.
Vì sao cần bảo quản vi sinh ở -86°C?
Vi sinh vật là những tế bào sống cực kỳ nhạy cảm với môi trường. Khi bảo quản ở điều kiện thường hoặc lạnh thông thường (4°C, -20°C), các hoạt động trao đổi chất vẫn diễn ra chậm, khiến:
- Tế bào dần bị thoái hóa, mất khả năng sinh trưởng.
- Hoạt tính enzyme suy giảm.
- Dễ xuất hiện đột biến hoặc biến đổi di truyền.
- Chất lượng và hiệu quả sản phẩm giảm rõ rệt.
Ngược lại, ở -86°C, tế bào vi sinh gần như “ngủ đông” – mọi hoạt động sinh học tạm ngưng. Điều này giúp giữ nguyên cấu trúc tế bào, bảo toàn enzyme, protein và vật chất di truyền, từ đó duy trì hoạt tính sinh học ổn định suốt nhiều năm.
Chính công nghệ này góp phần tạo nên nền tảng chất lượng bền vững cho toàn bộ dòng chế phẩm vi sinh Bio-Floc.
Quy trình bảo quản giống vi sinh tại Bio-Floc

Bio-Floc xây dựng quy trình khép kín, vô trùng tuyệt đối trong phòng thí nghiệm chuyên biệt – đảm bảo tiêu chuẩn nghiên cứu và sản xuất nghiêm ngặt:
Bước 1: Phân lập và định danh chủng vi sinh
Các chủng Bacillus, Lactobacillus,.. được phân lập từ nguồn tự nhiên, chọn lọc theo hoạt tính sinh học và khả năng thích ứng môi trường. Mỗi chủng đều được giải trình tự gen 16S rRNA, giúp xác định chính xác loài và đảm bảo tính ổn định, truy xuất được nguồn gốc khoa học.
Bước 2: Chuẩn hóa và kiểm tra hoạt tính chủng gốc
Chủng được nuôi tăng sinh ở quy mô phòng thí nghiệm để kiểm tra mật độ tế bào, khả năng tạo enzyme, sinh acid hữu cơ, đối kháng vi khuẩn gây bệnh và độ bền trong nhiều điều kiện khác nhau.
Bước 3: Lưu trữ trong tủ siêu lạnh -86°C
Sau khi đạt tiêu chuẩn, mẫu chủng được phối trộn với dung dịch bảo vệ tế bào (cryoprotectant) rồi chia nhỏ trong ống cryovial chuyên dụng. Tất cả được lưu trữ ở -86°C trong hệ thống giám sát tự động 24/7, có cảnh báo nhiệt độ tức thời, đảm bảo ổn định tuyệt đối.
Nhờ quy trình này, nguồn giống tại Bio-Floc luôn tinh khiết, ổn định và giữ nguyên hoạt tính sinh học gốc, phục vụ cho sản xuất lâu dài.
Ưu điểm vượt trội của công nghệ bảo quản -86°C tại Bio-Floc

Công nghệ bảo quản vi sinh ở -86°C giúp Bio-Floc duy trì toàn vẹn hoạt tính và độ tinh khiết của từng chủng vi sinh. Ở mức nhiệt siêu thấp này, tế bào gần như “ngủ đông”, mọi phản ứng sinh học tạm ngưng, giúp:
- Giữ hoạt tính sinh học tối đa, đảm bảo khả năng phân giải và đối kháng vi khuẩn gây hại.
- Duy trì độ tinh khiết và hình thái ban đầu, không bị tạp nhiễm hay biến đổi di truyền.
- Ổn định lâu dài, vẫn phát triển mạnh sau khi được hoạt hóa.
- Tăng hiệu suất sản xuất, nhờ nguồn giống gốc khỏe, đồng nhất giữa các lô.
Công nghệ bảo quản -86°C hiện được Bio-Floc áp dụng cho toàn bộ hệ thống giống gốc trong sản xuất nguyên liệu vi sinh, giúp đảm bảo chất lượng đồng nhất giữa các lô sản xuất, mang đến sản phẩm hoạt tính cao, an toàn và hiệu quả thực tế rõ rệt cho người nuôi.
Không chỉ dừng lại ở việc bảo quản, Bio-Floc đang xây dựng “Ngân hàng chủng vi sinh Bio-Floc” – nơi lưu trữ hàng trăm chủng vi sinh quý phục vụ nuôi trồng thủy sản và nông nghiệp bền vững.
Công nghệ bảo quản vi sinh ở –86°C là một trong những trụ cột công nghệ trong sản xuất của Bio-Floc, giúp doanh nghiệp luôn chủ động về nguồn giống, đảm bảo chất lượng sản phẩm ổn định và hiệu quả lâu dài.
Từ việc “giữ gốc” chuẩn xác, Bio-Floc tiếp tục phát triển chuỗi công nghệ hiện đại khác như lên men vi sinh tự động, lọc tiếp tuyến, và đông khô vi sinh – hình thành nên hệ thống sản xuất vi sinh hoàn chỉnh, tiên tiến và đáng tin cậy hàng đầu Việt Nam.
Tìm hiểu Quy trình nghiên cứu vi sinh hoạt tính cao tại Bio-Floc


